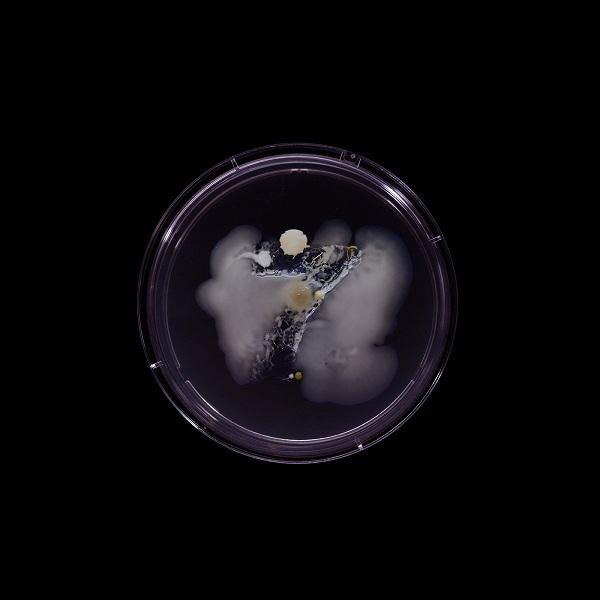
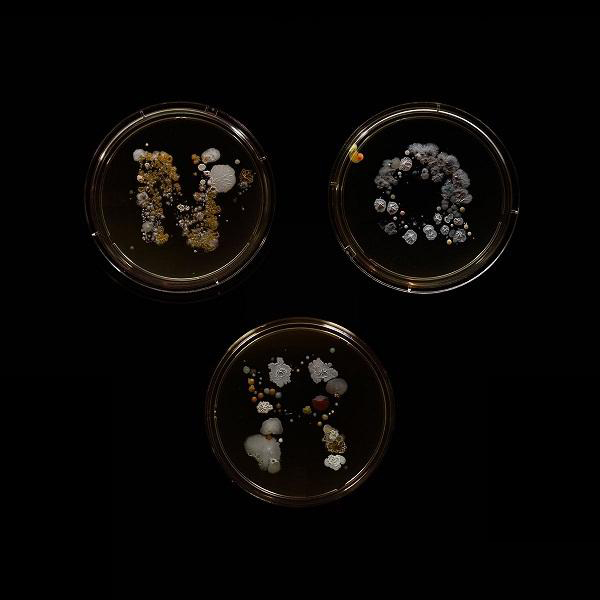
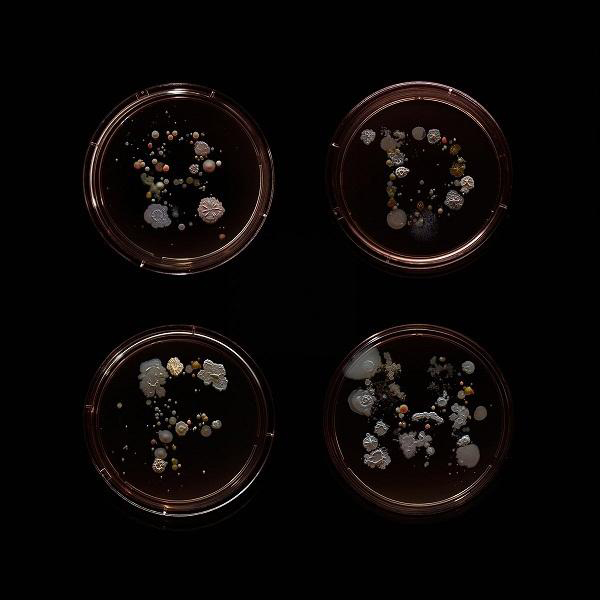

组图:显微镜曝光纽约地铁站暗藏的细菌

如果你有洁癖的话,看过这篇文章之后或许你会想要从此远离纽约市的地铁。如果你是一位摄影师,或许你也会像Craig Ward一样对这些细菌着迷。Ward今年夏天开始在纽约市的全部22条地铁路线上收集细菌样本,而且设法将这些细菌培养成地铁站名字的样式。虽然他的发现或许并非100%准确,但是他认为这些结果有一定的准确度。

为了收集样本,Ward将无菌海绵剪切成地铁线名字的样式。然后他将收集到的细菌密封到一个有盖培养皿中,让它们继续繁殖。

Ward是在地铁路线的非高峰期收集到的样本,此时的地铁不会非常拥挤。没有人曾经询问他为何频繁的擦拭地铁上的扶手。Ward称:“老实说你可以在地铁上随意做你想做的事情,人们相当的宽容。”

Ward称:“我的大多数发现都是非常常见的,不会比你与一群人握手时遭遇到的细菌多。”
Ward收集到的地铁细菌样本中包含金黄色酿脓葡萄球菌,它是皮肤感染、鼻窦炎和食物中毒的常见起因。细菌样本中还有藤黄微球菌,这是皮肤上的一种正常菌丛,它同样存在于唾液和汗水中。

纽约地铁42街接驳线收集到的细菌样本中包含大肠杆菌、沙门氏菌和金黄色酿脓葡萄球菌。大肠杆菌会引发肠胃炎和尿路感染,而且通常存在于下侧肠道内。

G号线地铁细菌样本中包含大肠杆菌、沙门氏菌、藤黄微球菌和枯草杆菌,枯草杆菌通常存在于土壤和人类的胃肠道中。

L号线地铁的细菌样本中包含大肠杆菌、奇异变形杆菌、藤黄微球菌、枯草杆菌和粘质沙雷氏菌。粘质沙雷氏菌是医院感染患者的首要起因。
Ward称他的发现事实上非常的漂亮,它们与城市多元化形成了一种精彩的视觉类比。
但是当他带着自己2岁大的女儿乘坐地铁时,他的想法却有所改变。Ward称:“我真的不希望看到她碰触扶手,然后再将手放进嘴里。”他所收集到的样本中,B、D、F和M线地铁都有大肠杆菌和金黄色酿脓葡萄球菌的存在,后者是皮肤感染、鼻窦炎和食物中毒的常见诱因。

发表你的评论吧返回顶部
!评论内容需包含中文
